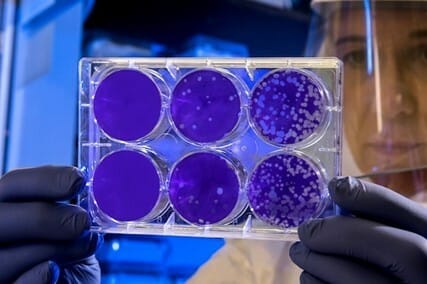

Lazy, hazy days
April 17, 2026


Chicago’s Saturday in the Park may have peaked at #3 on the Billboard Hot 100, but it brought Chicago V to #1 on the album charts. And what a tune. The jazzy pop banger truly captured the essence of a summery Saturday hang 😎
With the warm weather upon us soon, it’s hard not to be nostalgic for the summers of yesteryear. You ever think that summer felt endless as a kid? It turns out it’s because your sense of time was processed differently by your brain back then.
It really seemed to last forever ;)
(Love nostalgia? Play today’s trivia below. You could win a $25 eGift Card!)
Good morning Staker! Here’s what’s cookin’ today: A lesson in the ideal color for those raw steaks; What shade of red is best for raw steak; and a look at what happened when AI came for the illustrious Berklee College of Music! 🥊
But first our weekly poll!
OUR WEEKLY POLL
What are we thinking?

When was the last time you saw the dentist? |
FEASTING FRIDAYS
What color should raw steak be?

Giphy
Stakers love steak, so why should the week end with anything other than a lesson about it?
A study published last year in Food and Humanity found consumers tend to pick the brightest red steaks when looking through the glass at the butcher shop, convinced that cuts of this color and hue are the freshest and best tasting.
According to Evan Lobel, co-owner of the 72-year-old butcher shop Lobel’s of New York in Manhattan, it’s not necessarily the case that the freshest beef is whichever one is brightest red. He says beef is actually darker when at its freshest, and that darker cuts can taste just as good, if not better.
Lobel says he understands why consumers might think they’re onto something about the redness, but in reality, colour has more to do with exposure to oxygen than actual flavour.
He does, however, concede that coloring can have taste implications, because color can also have to do with how much marbling is still in the beef.
“Typically, more marbling in a cut will show as a lighter color and will affect the taste in a positive way,” says Lobel. “Conversely, less fat equals darker color and could mean a chewier steak…freshly cut beef is typically a deep purplish-red when first exposed.”
MEDICINE
Researchers discover “zombie” immune cells in people with fatty liver disease
Pexels
Researchers at UCLA found a population of immune cells in those with fatty liver disease that both stop dividing and refuse to die. These rogue “zombie” cells don’t just linger, but also send out signals that create inflammation in fatty livers, but also in all kinds of aging tissue.
The process is called cellular senescence and when the researchers removed these types of cells from mice with fatty liver disease, inflammation declined significantly and their liver health improved.
"Senescent cells are fairly rare, but think of them like a broken-down car on the 405," said Anthony Covarrubias, senior author of the study and a member of the Eli and Edythe Broad Center of Regenerative Medicine and Stem Cell Research at UCLA.
"Just one stalled car can back up traffic for miles. Now imagine five or ten of them slowly accumulating. That's what these cells do to a tissue: even a small number causes enormous disruption."
These immune cells are called macrophages, and they’re tasked with patrolling all tissue in the body and destroying threats to it. Conventional wisdom in the field of biology has suggested macrophages could not themselves become senescent, but simply display some biomarkers of senescence, even when healthy.
The UCLA research suggests the conventional wisdom is incorrect.
SPACE
Scientists measure speed and power of a black hole jet

NASA/Unsplash
It’s not possible for the human mind to comprehend the speed and power of a jet shooting out of a black hole, but scientists from the University of Oxford finally managed to measure them.
While studying abroad at Australia’s Curtin University, astronomer Steve Prabu and his team put together 18 years worth of radio imaging captured by a global network of telescopes that were focused on Cygnus X-1, the black hole-blue giant binary system located roughly 7,200 lightyears from Earth.
The black hole is constantly being fed by gas from the star in this system, creating an accretion disc the temperature and speed of which are difficult to imagine.
It’s not fully clear why jets shoot out of black holes, but think of it like what would happen if you sprayed a constant stream of water on a buzz saw spinning at maximum speed.
In the case of Cygnus X-1, Prabu was able to identify the speed and power of the black hole’s jets by measuring the degree to which they were bent by the stellar winds of the object’s companion star.
Prabu calculated these particular jets are shooting out of the black hole at half the speed of light, or 355 million miles per hour. Their energy is equivalent to that of 10,000 suns.
Now consider the fact that Cygnus X-1 is a baby compared to others. A pair of black holes discovered two years ago have jets that span 23 million lightyears, or the diameter of 140 Milky Ways. 🤯
MUSIC
Berklee students drawing the line at “AI in music” class

Giphy
The Berklee College of Music plans to offer a course next semester entitled “Bots and Beats: AI and the Future of Songwriting.”
The course will “explore how music makers can use the latest AI tools to expand their craft, and how to avoid using those same tools in a way that hinders their craft,” and examine “the impact of AI on the music industry (both helpful and harmful), and on the future careers of music makers, as well as the role of musicians and creators in a society with abundant access to music creation.”
This may seem like a balanced approach about the inevitable evolution of music as an artform and an industry. The students, however, took exception to the part about “generating original lyrics, melodies, songs, and recordings in collaboration with AI.”
A petition protesting the course has been signed by between thousands of students, which reads, “AI models like ChatGPT that are being promoted by the Berklee Songwriting Department steal the art of 10’s of 1000’s of artists and rot the essence of the industry and have devastating consequences on the environment all to create facsimiles of real human art.”
Asked about the petition, the school’s administration told a local Boston news station, “as an artist-first institution at the forefront of contemporary music and performing arts education, Berklee has a responsibility to prepare our students to navigate technologies impacting the creative industries. We will continue to do so, in keeping with our guiding principles.”
STAKE TRIVIA
What’s it gonna be

Giphy
It’s Friday and you know what that means! Time for trivia à la carte. It’s a little of this, a little of that, and a whole lotta fun.
Give today’s trivia a try and you might just win a $25 e-gift card.
Winner will be notified on Monday afternoon. Keep an eye on your inbox and don’t forget to check your spam folder! *
Have a great weekend Staker!
Today’s issue written by Michael Cowan, Joey Cowan, and Maureen Norman.
*SEE FULL STAKE TRIVIA CONTEST RULES HERE.